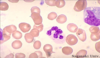

Haem: Myelodysplastic syndromes and Aplastic anaemia Flashcards
(40 cards)
Define myelodysplastic syndrome.
Biologically heterogenous group of acquired haematological stem cell disorders.
What are the key characteristics of myelodysplastic syndromes?
- Development of a clone of marrow stem cell with abnormal maturation resulting in functionally defective blood cells and a reduction in cell counts
- This leads to cytopaenia, functional abnormalities of cell maturation and an increased risk of transformation to leukaemia
Which types of patients tend to develop myelodysplastic syndromes?
Elderly
How do myelodysplastic syndromes typically present?
Symptoms/signs of bone marrow failure developing over weeks/months
List and describe some blood and bone marrow features of myelodysplastic syndromes.
- Pelger-Huet anomaly (bilobed neutrophils)
- Dysgranulopoeisis of neutrophils (failure of granulation)
- Dyserythropoiesis of red blood cells (lack of separation between red cell precursors, presence of abnormal ring of cytoplasm around the nucleus of percursor red cells)
- Dysplastic megakaryocytes (micro-megakaryocytes)
- Increased proportion of blast cells in the bone marrow (normally < 5%)
What does this image show?

Pelger-Huet anomaly

What does this image show?

Refractury anaemia dysgranulopoiesis (failure of neutrophil granulation)
What does this image show?

Refractory anaemia-dyserythropoiesis of red blooc cells (lack of separation between red cell precursors, presence of abnormal ring of cytoplasm around the nucleus of precursor red cells)

What does this image show?

Ringed sideroblast (accumulation of iron around the nuclei of red blood cell precursors)

What might you see if you stained for iron in the bone marrow of a patient with a myelodysplastic syndrome?
Ringed sideroblasts (accumulation of iron around the nuclei of red blood cell precursors)

What is the presence of myeloblasts with Auer rods suggestive of?
Acute myeloid leukaemia.

List some factors that are taken into account when classifying types of myelodysplastic syndrome.
- Cell lineage affected
- Blast cell proportions
- Cytogenetics
- Presence of ringed sideroblasts
- Cytopaenia
What are the five prognostic variables that are used to calculate prognostic risk using the Revised International Prognostic Scoring System (IPSS-R) for Myelodysplastic Syndromes?
- Bone marrow blast percentage
- Karyotype
- Haemoglobin
- Platelets
- Neutrophils
NOTE: high risk is considered a score > 6, low risk ≤ 1.5
How does myelodysplasia tend to evolve from the time of diagnosis?
Blood counts will decrease (leading to worsening bone marrow failure)
Some patients will develop acute myeloid leukaemia (poor prognosis)
What are the usual causes of death in patients with myelodysplasia?
- 1/3 infection
- 1/3 bleeding
- 1/3 leukaemia
What are the two treatments that can prolong life in myelodysplastic syndromes?
- Allogeneic stem cell transplantation
- Intensive chemotherapy
NOTE: as most MDS patients are elderly, they often cannot tolerate treatment
List some other treatments that may be used in myelodysplastic syndromes.
- Supportive Care (blood products, antimicrobials, growth factors (e.g. EPO, GM-CSF)
- Biological modifiers
- Immunosuppression
- Azacytidine (hypomethylating agent)
- Decitabine
- Lenalidomide (used in 5q minus syndrome)
- Oral chemotherapy (e.g. hydroxyurea)
- Low-dose chemotherapy (SC low-dose cytarabine)
List some causes of primary bone marrow failure.
- Fanconi anaemia (multipotent stem cell)
- Diamond-Blackfan syndrome (red cell progenitor)
- Kostmann syndrome (neutrophil progenitor)
- Acquired: idiopathic aplastic anaemia (multipotent stem cell)
List some secondary causes of bone marrow failure.
- Marrow infiltration
- Haematological malignancies
- Solid tumours spreading to bone marrow
- Radiation
- Drugs
- Chemicals (e.g. benzene)
- Autoimmune
- Infection (e.g. parvovirus B19)
List some drugs that can cause bone marrow failure.
- Cytotoxic drugs (predicatble, dose-dependent)
- Phenylbutazone, Gold salts (idiosyncratic, rare)
- Antibiotics - chloramphenicol, sulphonamides
- Diuretics - thiazide
- Antithyroid drugs - carbimazole
Which age groups are affected by aplastic anaemia?
- All age groups (mainly 15-24 and 60+)
NOTE: this is much more rare than MDS
What is the most common cause of aplastic anaemia?
Idiopathic (70-80%)
List some inherited causes of aplastic anaemia.
- Fanconi anaemia
- Schwachman-Diamond syndrome
- Dyskeratosis Congenita
Outline the possible pathophysiology of idiopathic aplastic anaemia.
- Characterised by failure of the bone marrow to produce blood cells
- Either due to an inherent issue with the stem cells or due to autoimmune attack on stem cells